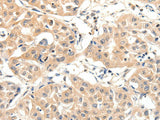
SLC27A1 Polyclonal Antibody Store at -20°C

SLC27A1 Polyclonal Antibody Store at -20°C
SKU: E-AB-12872-200
SLC27A1 Polyclonal Antibody Store at -20°C
| SKU # | E-AB-12872 |
| Reactivity | Human |
| Host | Rabbit |
| Applications | IHC |
Product Details
| Isotype | IgG |
| Host | Rabbit |
| Reactivity | Human |
| Applications | IHC |
| Clonality | Polyclonal |
| Immunogen | Synthetic peptide of human SLC27A1 |
| Abbre | SLC27A1 |
| Synonyms | ACSVL5, FATP, FATP 1, FATP1, FLJ00336, Fatty acid transport protein 1, Long chain fatty acid transport protein 1, MGC71751, SLC27A1, Solute carrier family 27 (fatty acid transporter) member 1, Solute carrier family 27 member 1 |
| Swissprot | |
| Cellular Localization | Cell membrane, Single-pass membrane protein, Intracytoplasmic membrane, Single-pass membrane protein, Cytoplasm, Note=Plasma membrane and intracellular membranes, at least in adipocytes, Predominantly cytoplasmic in myocytes. |
| Concentration | 0.1 mg/mL |
| Buffer | Phosphate buffered solution, pH 7.4, containing 0.05% stabilizer and 50% glycerol. |
| Purification Method | Affinity purification |
| Research Areas | Cancer, Cardiovascular, Metabolism, Signal Transduction |
| Conjugation | Unconjugated |
| Storage | Store at -20°C Valid for 12 months. Avoid freeze / thaw cycles. |
| Shipping | The product is shipped with ice pack,upon receipt,store it immediately at the temperature recommended. |
Related Reagents
| Applications | Recommended Dilution |
| IHC | 1:50-1:200 |
Background
The protein involved in translocation of long-chain fatty acids (LFCA) across the plasma membrane. The LFCA import appears to be hormone-regulated in a tissue-specific manner. In adipocytes, but not myocytes, insulin induces a rapid translocation of FATP1 from intracellular compartments to the plasma membrane, paralleled by increased LFCA uptake. Plays a pivotal role in regulating available LFCA substrates from exogenous sources in tissues undergoing high levels of beta-oxidation or triglyceride synthesis. May be involved in regulation of cholesterol metabolism. Has acyl-CoA ligase activity for long-chain and very-long-chain fatty acids .Highest levels of expression are detected in muscle and adipose tissue small, intermediate levels in small intestine, and barely detectable in liver.